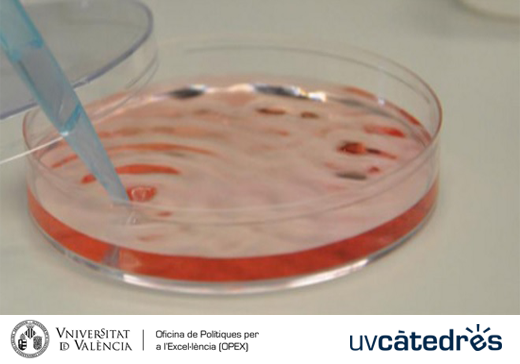

En el marc de les activitats organitzades per la Càtedra FISABIO-UV per al foment de la investigació biomèdica tindrà lloc una conferència centrada en la incidència del microfong Pneumocystis en xiquets.
La conferència, titulada “Infecció subclínica per Pneumocystis en xiquets com a tema emergent de salut pública”, serà impartida pel professor Sergio Vargas de l’Institut de Ciències Biomèdiques de la Facultat de Medicina de la Universitat de Xile. Aquesta ponència tindrà com a eix principal l’actualització dels estudis d’epidemiologia molecular que documenten la prevalença de la infecció per Pneumocystis en xiquets i adults immunocompetents, amb l’objectiu de millorar els índexs de salut i la prevenció d’aquesta infecció pulmonar.
Aquesta activitat tindrà lloc el pròxim dijous 5 d’octubre a partir de les 13 hores en la seu de la Fundació per al Foment de la Investigació Sanitària i Biomèdica de la Comunitat Valenciana, situada en l’Av. Catalunya núm. 21. Les inscripcions a la conferència s’han d’emplenar en el següent formulari o enviant un correu electrònic a fernandez_patsai@gva.es.